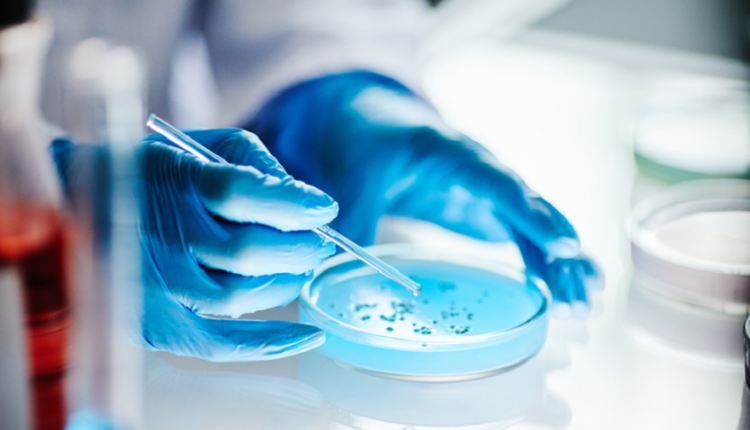

تحذير للسائقين.. عنصر أساسي في السيارة مليء بالجراثيم!
يتعامل الناس يوميا مع أشياء كثيرة دون التفكير في تأثيرها الخفي أو ما قد تحمله من مفاجآت غير مرئية.
وبهذا الصدد، حذرت دراسة جديدة من أن مفاتيح السيارات تحتوي على عدد بكتيريا أكبر بأربع مرات تقريبا مقارنة بالهواتف المحمولة ولوحات مفاتيح الحواسيب.
وأجرى خبراء Money Supermarket الدراسة التي شملت 2000 سائق في المملكة المتحدة، حيث كشفوا أن ثلث السائقين لم ينظفوا مفاتيح سياراتهم قط، رغم امتلاك كثيرين لها لأكثر من 5 سنوات.
كما أخذ فريق البحث مسحات من مفاتيح السيارات لتحليلها في مختبر متخصص، ووجدوا أن متوسط عدد البكتيريا على مفاتيح السيارات بلغ 241، مقارنة بـ66 على الهواتف المحمولة و68 على لوحات مفاتيح الحواسيب. وكان مقعد المرحاض الأكثر تلوثا بعدد 1100 بكتيريا، لكن الباحثين يخشون أن يكون التلوث على المفاتيح أكثر مما تم تقديره.
وتعد المكورات العنقودية البشرية (كائنات حية تعيش بشكل طبيعي على جلد الإنسان) أكثر أنواع البكتيريا شيوعا على مفاتيح السيارات، وهي عادة غير ضارة، لكن بعض سلالاتها قد تسبب عدوى خطيرة، خصوصا مع تطورها لمقاومة المضادات الحيوية.
وينصح الخبراء بتنظيف مفاتيح السيارات بانتظام باستخدام قطعة قماش ناعمة ومحلول صابون معتدل، مع تجنب المبيضات وغمر المفاتيح في الماء لتفادي تلف المكونات الإلكترونية.
ويختلف معدل تنظيف المفاتيح بين سائقي الماركات، حيث تتصدر بي إم دبليو القائمة بنسبة 57% تنظيف أسبوعي أو أكثر.
نشرت النتائج على موقع Money Supermarket، مؤكدة أهمية الانتباه لنظافة مفاتيح السيارات لتقليل خطر انتقال البكتيريا.